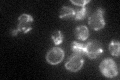
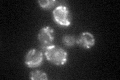

View description
Protein subunit of mitochondrial RNase P, has roles in nuclear transcription, cytoplasmic and mitochondrial RNA processing, and mitochondrial translation; distributed to mitochondria, cytoplasmic processing bodies, and the nucleus
Localization:
Intensity:
Fold change:
Significance:
-
C’ GFP library in SD
mitochondria35.69 -
N' NOP1pr-GFP in SD

mitochondria70.1719 -
N' TEF2pr-mCherry in SD

mitochondriaN/A -
N' NATIVEpr-GFP in SD

missing0 -
N' TEF2pr-VC and Cyto-VN in SD

#N/A0 -
C’ GFP library in SD+DTT
mitochondria31.320.87No -
C’ GFP library in SD+H2O2

mitochondria38.831.08No -
C’ GFP library in Starvation Media

mitochondria27.560.77No -
C’ GFP library on the background of Pup2-DaMP

mitochondria -
C’ GFP library on the background of CCT mutant

mitochondria44.52821.2473No
